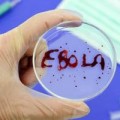
Tin tức - Khi xuất hiện người nhiễm Ebola, Việt Nam sẽ làm gì?

Tổ chức Y tế Thế giới vừa xác nhận đã có ít nhất một trường hợp tử vong vì nhiễm virus Ebola ở tỉnh Bas-Uele, Congo.
Reuters đưa tin, mới đây Tổ chức Y tế thế giới WHO đã tuyên bố đại dịch Ebola bùng phát trở lại tại Công hòa Dân chủ Congo khi có ít nhất một người đã thiệt mạng sau khi nhiễm virus chết người này.
Được biết, vào ngày 22/4, tại tỉnh Bas-Uele, vùng đông bắc Congo có 9 người tử vong do sốt xuất huyết. Ngày 10/5, Bộ Y tế CHDC Congo thông báo với WHO rằng trong số 5 mẫu máu được kiểm tra tại phòng thí nghiệm nghiên cứu Y sinh thuộc Viện Quốc gia tại thủ đô Kinshasa, có 1 mẫu dương tính với chủng Zaire của virus Ebola.
Có ít nhất 1 người tử vong vì nhiễm virus Ebola tại Congo
Những người nghi nhiễm virus Ebola có dấu hiệu ốm từ ngày 22/4 tại tỉnh Bas-Uele. Khu vực này cách xa thủ đô Kinshasa 1,300km, gần với biên giới cộng hòa Trung Phi.
Bộ trưởng Y tế Cộng hòa Dân chủ Congo cho hay: “Chúng tôi đang phải đối mặt với một đợt bùng phát virus Ebola có thể phát sinh cuộc khủng hoảng y tế quốc tế”. Tuy nhiên ông cũng keu gọi mọi người 'đừng hoảng sợ'. Nhà nước Congo đã thực hiện tất cả các biện pháp cần thiết để đáp ứng một cách nhanh chóng và hiệu quả dịch bệnh này.
Eugene Kabambi, người phát ngôn của WHO tại Cộng hòa Dân chủ Congo cho biết khu vực phát hiện Eboka là một vùng rất hẻo lánh và ít dân cư nên ổ dịch sẽ khó bùng phát nhanh được.
Virus chết người Ebola từng giết chết hơn 11.300 hồi năm 2014-2015
Hồi năm 2014-2015, đại dịch Ebola bùng phát đã giết chết hơn 11.300 người và 28.600 người khác bị nhiễm bệnh, chủ yếu tại các nước như Guinea, Sierra Leone và Liberia.
Cuộc bùng phát mới nhất của dịch Ebola tại Cộng hòa Congo là vào năm 2014, gây ra cái chết cho hơn 40 người.
WHO gần đây đã phát triển một loại vắc xin Ebola mới để sử dụng trong trường hợp dịch Ebola bùng phát. Tiến sĩ Seth Berkleycho biết: "Hiện có 300.000 liều vắc xin Ebola sẵn sàng để ngăn chặn vụ bộc phát này trở thành đại dịch".